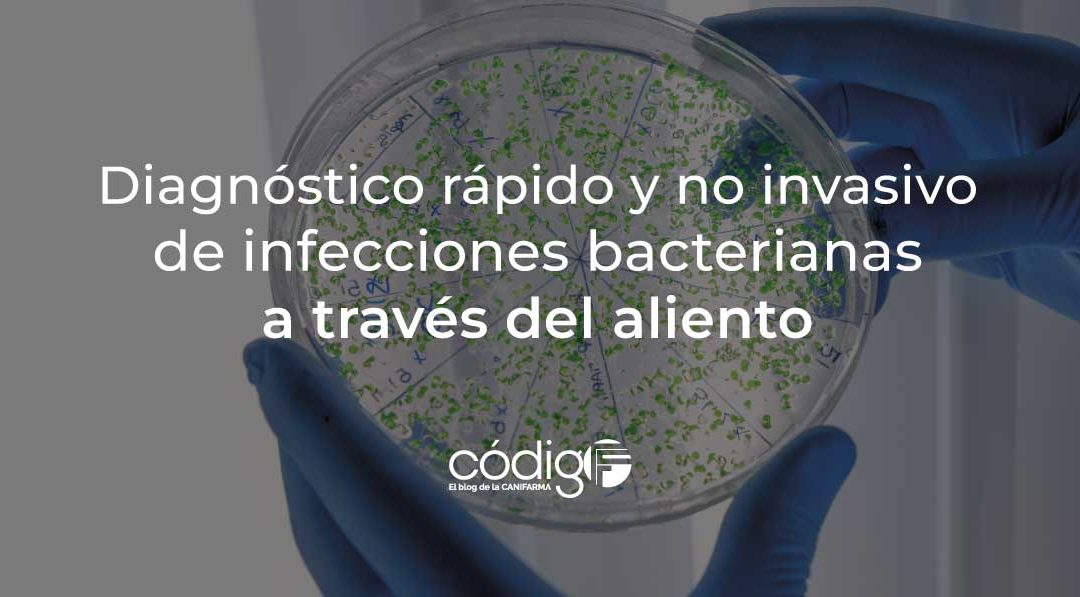
TestInfeccionesBacterianasAliento

Con la introducción del chikungunya a partir del 2013, y del Zika desde 2015 en la Región de las Américas y del Caribe, enfermedades que se suman al permanente desafío del virus del Nilo occidental, el dengue, la fiebre amarilla y otros arbovirus, es indispensable mantener e incrementar una vigilancia coordinada, oportuna, rápida y eficaz.
A mediados del mes de agosto, se llevó a cabo la reunión anual de los especialistas que conforman la Red de Laboratorios de Diagnóstico de Arbovirus (RELDA) de las Américas, con el objetivo de fortalecer las acciones coordinadas para la detección y vigilancia oportuna de las enfermedades transmitidas por la picadura de artrópodos: mosquitos, garrapatas y jejenes.
La reunión se da en un momento coyuntural, ante la evidencia que muestra el incremento de los brotes de dengue, y la expansión del chikungunya, enfermedades que afectan cada vez a un mayor número de pobladores de la región.
RELDA está formada por 40 laboratorios, asesores técnicos y centros colaboradores de la OMS, y es el brazo operativo del componente de laboratorio de la Estrategia para la prevención y el control de las enfermedades arbovirales de la OPS, conocida como EGI-Arbovirus, cuyo principal objetivo es el de garantizar una vigilancia de laboratorio eficiente, y una capacidad instalada robusta para responder a brotes y epidemias de los arbovirus.
Durante el evento, Sylvain Aldighieri, Director Adjunto del Departamento de Emergencias en Salud de la OPS, declaró: “Al menos nueve arbovirus con impacto en la salud pública -como dengue, Zika, chikungunya y fiebre amarilla- circulan en Latinoamérica y el Caribe, por lo que fortalecer y ampliar las capacidades de detección y vigilancia por laboratorio es clave para asegurar una respuesta oportuna ante brotes y epidemias”.
“Los virus transmitidos por artrópodos (Arbovirus), como el dengue, la fiebre amarilla, el chikungunya y el Zika, son amenazas actuales para la salud pública en áreas tropicales y subtropicales donde viven aproximadamente 3900 millones de personas. La frecuencia y magnitud de los brotes de estos arbovirus, en particular los transmitidos por los mosquitos Aedes, están aumentando a nivel mundial, impulsados por la convergencia de factores ecológicos, económicos y sociales”. Iniciativa Global de Arbovirus.
Poniendo en cifras el problema, les informamos que desde el inicio del año, y hasta finales de julio del presente, se han documentado en la región más de 3 millones de nuevas infecciones por dengue, más de 324 mil casos de chikungunya, 27 mil casos de Zika, y algunos brotes esporádicos de fiebre amarilla, los que mantienen en estado alerta a las autoridades sanitarias, por la gran letalidad que puede alcanzar esta última enfermedad.
“El cuadro epidemiológico de las arbovirosis en la región es de una alta complejidad debido al potencial epidémico de estas enfermedades. Debemos llevar adelante una estrategia de prevención y control integrada que utilice las nuevas innovaciones para seguirle de cerca los pasos a estos virus desde el laboratorio”. José Luis San Martín, asesor regional en enfermedades arbovirales de la OPS.
Como parte del evento, los expertos analizaron la situación de la vigilancia entomovirológica en la región, o sea, la detección de los virus en los mosquitos antes de que lleguen a los humanos, un sistema de alerta temprana que permite anticipar brotes o epidemias por arbovirus, para implementar una respuesta más oportuna.
“La OPS comenzó a impulsar la vigilancia entomovirológica en 2017 y creó la Red de Laboratorios de Entomo-Virología de las Américas (RELEVA) que integran actualmente laboratorios de 14 países. En el encuentro, se presentaron y discutieron guías para esta vigilancia. A su vez, los laboratorios de la red están trabajando en un plan para su implementación. Prevén, además, crear una plataforma de vigilancia integral de arbovirus que incluya los datos de la vigilancia en mosquitos”. Organización Panamericana de la Salud.
Vale la pena comentarles que durante la pandemia de COVID-19, la vigilancia genómica de SARS-CoV-2 demostró ser una herramienta clave para conocer el virus, sus variantes y asesorar las políticas públicas para combatir la enfermedad.
Por: Manuel Garrod, miembro del Comité Editorial de códigoF.
Fuentes:
Organización Panamericana de la Salud. (16 de agosto del 2023).
Las Américas busca expandir la vigilancia genómica a dengue, chikungunya y otros virus transmitidos por mosquitos.
Organización Panamericana de la Salud. (s.f.).
Red de Laboratorios de Diagnóstico de Arbovirus (RELDA).